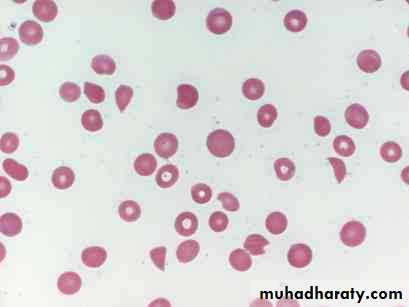

BLEEDING TENDENCY
Dr. Hayder Hadi Al-Musawi4/3/15
1
HEMOSTASIS
When blood vessels are injured, the clotting process causes blood flow to cease through the injured vessel.If clotting is impaired, hemorrhage occurs.
If clotting is excessive, thrombosis and its complications occur.
Small blood vessels : vasoconstriction + platelet
Large blood vessels: full hemostatic process to provide a firm stable fibrin clot.
The extent of clotting is localized by the anticoagulant system. The removal of the clot requires appropriate fibrinolysis.
4/3/15
2
tPA: tissue plasminogen activator.
FDPs: fibrin degradation products.IDIOPATHIC THROMBOCYTOPENIC PURPURA(ITP)
4/3/156
Etiology
ITP is the most common cause for acute onset thrombocytopenia in an otherwise well healthy child.One to four weeks following exposure to a common viral infection, a small number of children develop an autoantibody directed against the platelet surface.
4/3/15
7
Clinical manifestations
The classic presentation of ITP is that of a perfectly healthy 1- to 4-yr-old child who has the sudden onset of generalized petechiae and purpura. The parents often state that the child was fine yesterday and now is covered with bruises and purple dots. Often there is bleeding from the gums and mucous membrane.
Less than 1% of cases develop intracranial hemorrhage.
Minority of children who present with acute ITP go on to develop chronic ITP.
4/3/15
84/3/15
94/3/15
10Laboratory findings
• Severe thrombocytopenia (platelet count <20 × 109 /L) is common.• The hemoglobin may be decreased if there have been profuse nosebleeds or menorrhagia.
• Coombs test should be done if there is unexplained anemia to rule out Evans syndrome (autoimmune hemolytic anemia and thrombocytopenia).
• The bone marrow examination, reveals normal or increased numbers of megakaryocytes.
4/3/15
11
Low peripheral platelet count with increased bone morrow megakaryocytes
4/3/15
12Treatment 1
• Treatment appears to be capable of inducing a more rapid rise in platelet count to the theoretically safe level of 20,000/mm3.• Most of children will have spontaneous resolution of their ITP within 6 months.
• Initial treatment options include the following:
• Intravenous immunoglobulin
• IVIG for 1–2 days induces a rapid rise in platelet count (usually >20 × 109 /L) within 2days.
4/3/15
13
Treatment 2
• Prednisone:
• Doses of 1–4 mg/kg/24 hr of prednisone.
• Corticosteroid therapy is usually continued for 2 to 3 wk or until a rise in platelet count above 20,000 has been achieved with a rapid taper to avoid the long-term side effects.
• IV Anti-D Therapy :
• The role of IV anti-D in initial therapy of acute ITP is under investigation.
4/3/15
14
Treatment 3
• Splenectomy• The role of splenectomy in ITP should be reserved for one of the following circumstances:
• The older child (4 yr) with severe ITP that has lasted longer than 6 months (chronic ITP).
• Splenectomy must also be considered when life-threatening hemorrhage (intracranial hemorrhage).
• Failure of other treatment options.
4/3/15
15
HEMOPHILIA A & B
4/3/1516
Factor VIII and factor IX deficiencies are the most common severe inherited bleeding disorders
4/3/15
17
Pathophysiology 1
PT (Prothrombin Time): is prolonged if any deficiency is found in the extrinsic pathway.PTT (Partial Thromboplastin Time): is prolonged if any deficiency is found in the intrinsic pathway.
TT (Thrombin Time): is prolonged if any deficiency is found in the common pathway.
4/3/15
19Pathophysiology 2
In hemophilia A (factor VIII deficiency) or hemophilia B ( factor IX deficiency) , the clot formation is delayed and is not robust.The clot that is formed may be friable, and rebleeding occurs during the physiologic lysis of clots or with minimal trauma.
4/3/15
20
Clinical manifestation 1
Neither factor VIII nor factor IX crosses the placenta; thus, bleeding symptoms may be present from birth or occur in the fetus.
Evidences of increased bleeding such as easy bruising.
Although bleeding may occur in any area of the body, the hallmark of hemophilia is the hemarthrosis. Bleeding into joints may be induced by minor trauma; nonetheless, many hemarthroses are spontaneous.
Life-threatening bleeding in the hemophilic patient is caused by:
Bleeding into vital structures (CNS, upper airway).
Exsanguination (external, gastrointestinal, or iliopsoas hemorrhage).
4/3/15
21
4/3/15
224/3/15
234/3/15
24Laboratory findings
PTT is prolonged.PT, TT, PL , BT (bleeding time), are normal.
The confirmatory test is the specific assay for factor VIII and factor IX
Mixing of normal plasma with patient plasma results in correction of the PTT. If correction does not occur on mixing, an inhibitor may be presentIn such patients the quantitative assay for inhibitor should be performed.
4/3/15
25
Genetics
Hemophilia is an X – linked recessive disorder, so it occurs mainly in males.Some female carriers of hemophilia A or hemophilia B will have sufficient reduction of their factor VIII or factor IX through lionization of the X chromosome (bar body), or even gene mutation, to produce mild bleeding disorders in carriers.
4/3/15
26
Treatment
• General measures:• Avoidance of trauma; a course between over protection and permissiveness should be followed.
• Avoid deep I.V and I.M injections.
• Avoidance of aspirin and other NSAID because it produce platelet dysfunction.
• Immunization against hepatitis B early in the neonatal period.
• Regular screening for hepatitis and abnormalities in LFT (Liver Function Test).
4/3/15
28
• Calculation of the dose of factors VIII & IX:
• Dose of FVIII (unit, U)=• (u/dl(%) desired raised in plasma FVIII) x body weight ( Kg) x 0.5
• Dose of FIX (unit, U)=
• (u/dl(%) desired raised in plasma FIX) x body weight ( Kg) x 1.0
4/3/15
29
4/3/15
30• Replacement therapy
• Type of bleeding
• Desired % rise of
• FVIII
• Desired % rise of
• FIX
• Hemarthrosis
• Other bleedings
• 50%
• 30%
• Major surgery or life - threatening hemorrhage
• Iliopsoas muscle
• 100%
• 80%
4/3/15
31Hemophilia A :
• Half life of factor VIII in the plasma is about 12 hours.
• Repeated infusions can be given as necessary to maintain the desire level of activity.
• 3 ways to give factor VIII :
Cryoprecipitate: one bag prepared from 250 ml of plasma. It is the most inexpensive; it contains 100 U of F VIII.
One bag / 5 kg will raise the recipient’s level to about 50%.
F VIII concentrate: more expensive than cryoprecipitate.
4/3/15
32
Desmopressin: With mild factor VIII hemophilia, the patient's endogenously produced factor VIII can be released by the administration of desmopressin acetate (DDAVP).
it is given either by an intranasal spray or parenteraly.
Hemophilia B :
We have 2 ways to give factor IX :• FFP (fresh frozen plasma).
• Factor IX concentrate.
3) Gene Therapy : is a hope and may be available in the near future.
Complications• Chronic joint destruction:
• Transfusion-transmitted infectious diseases:
• Development of an inhibitor to either factor VIII or factor IX:
• may need to go through desensitization programs, in which high doses of factor VIII or factor IX are infused in an attempt to saturate the antibody.
• If desensitization fails, these patients are treated with either activated prothrombin complex concentrates or factor VIIa. The use of these products bypasses the inhibitor in many instances but increases the risk for thrombosis.
4/3/15
34VON WILLEBRAND DISEASE
4/3/15
35
4/3/15
36Von Willebrand disease is the most common hereditary bleeding disorder.
Is inherited autosomally, but most centers report more women than men, as menorrhagia is a major symptom.In boys, abnormal bleeding after circumcision is a major finding.
Classification
Type 1 (most common): VWF (protein) is quantitatively reduced but not absentType 2: the protein is qualitatively abnormal
Type 3 (most sever): the protein is absent
4/3/15
37
Pathophysiology
Von Willebrand factor (VWf) is important for platelet adhesion & aggregation.VWF also serves as the carrier protein for plasma factor VIII. Deficiency of vWf may cause a secondary deficiency in factor VIII.
4/3/15
38
4/3/15
39
Clinical manifestation
Patients with von Willebrand disease usually have symptoms of mucocutaneous hemorrhage, including excessive bruising, epistaxis, menorrhagia, and postoperative hemorrhage, particularly after mucosal surgery such as tonsillectomy or wisdom tooth extraction.In homozygous von Willebrand disease (type 3), bleeding symptoms are much more profound &may have joint or spontaneous CNS hemorrhages.
4/3/15
40
Laboratory findings
• PTT : prolonged.• BT : prolonged.
• PL (Platelet count) & TT : normal.
These tests are not universally prolonged except in patients with type 3.
So to confirm the diagnosis :
• Quantitative assay for VWf antigen.
• VWf activity.
4/3/15
41
Treatment
the synthetic drug DDAVP (desmopressin) induces the release of vWf from the endothelial cells.
replacement therapy of vWf, if no response to DDAVP.
4/3/15
42